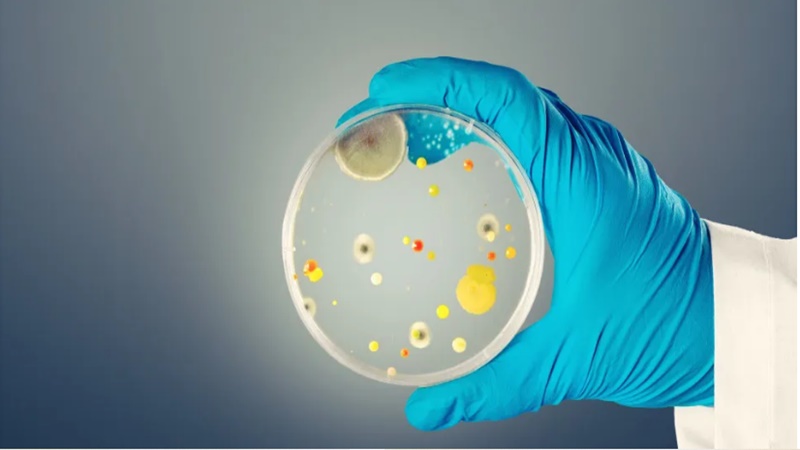

Da Redação do Aconteceu Ipu
Alerta mundial em crescimento
O Candida auris, um fungo considerado altamente perigoso, tem preocupado autoridades de saúde em diversos continentes. Ele já foi identificado em mais de 40 países e avança de forma silenciosa dentro de hospitais, colocando em risco principalmente pacientes com imunidade fragilizada.
Casos recentes assustam Europa
Em Portugal, quatro infecções foram confirmadas entre 2013 e 2023. Já no Reino Unido, os números cresceram rapidamente: entre novembro de 2024 e abril de 2025, foram 134 registros, representando aumento de 23% em relação ao semestre anterior.
Taxa de mortalidade elevada
Embora pessoas saudáveis possam apresentar apenas sintomas leves, o quadro é bem mais grave em pacientes debilitados. Estudos estimam que entre 30% e 60% dos infectados pelo fungo não resistem quando ele atinge órgãos vitais, como cérebro e coração.
Resistência aos tratamentos preocupa
O Candida auris foi identificado pela primeira vez no Japão em 2009. Desde então, tem se mostrado resistente aos principais medicamentos antifúngicos. Além disso, consegue sobreviver por longos períodos em superfícies hospitalares e se espalhar por equipamentos médicos contaminados, mesmo em pacientes assintomáticos.
Dificuldade no diagnóstico
A infecção pode provocar inflamações graves no sangue e em outros órgãos, mas a detecção precoce nem sempre é possível. Esse fator torna a prevenção ainda mais essencial.
Medidas de contenção
Especialistas orientam cuidados semelhantes aos de outras infecções hospitalares: higienização rigorosa das mãos, isolamento de pacientes infectados, uso de equipamentos descartáveis e limpeza intensiva das áreas hospitalares.
Números crescem na União Europeia
Segundo o Centro Europeu de Prevenção e Controle de Doenças, mais de 4 mil casos já foram confirmados no bloco europeu. Em 2023, foram registradas 1.346 infecções em 18 países, um aumento que acende um sinal vermelho sobre o risco de surtos cada vez mais frequentes.
Conteúdo NOTÍCIAS AO MINUTO
** Postagem: Virginia Aragão Soares
(Direto da Redação do Aconteceu Ipu)

 ➡ Chegou em Ipu o consultório veterinário que realmente pensa no seu pet! Um lugar comprometido em proporcionar toda dedicação e cuidado que seu melhor amigo merece! ➡ Oferecemos atendimento 24 horas e em domicílio, produtos e
➡ Chegou em Ipu o consultório veterinário que realmente pensa no seu pet! Um lugar comprometido em proporcionar toda dedicação e cuidado que seu melhor amigo merece! ➡ Oferecemos atendimento 24 horas e em domicílio, produtos e
medicamentos veterinários. Estamos localizados na rua Coronel Pedro Aragão, 1366, Centro, Ipu, Ceará. Nosso telefone para contato: ➡ (88) 99965-4115 Acompanhe nossas novidades, nos seguindo em nosso Instagram @dra.kamilasoaresvet.
 Olá visitantes e seguidores do nosso site Portal de Notícias Aconteceu Ipu estamos com uma nova plataforma de notícias aberto para sua propaganda com diversos tamanhos de banner’s e preço que cabe no seu bolso. Faça sua propaganda em nosso site e tenha seu produto sendo visualizado diariamente por milhares de internautas que acompanham o nosso trabalho de divulgação, destacados em nossas notícias e nas redes sociais: Instagram, Facebook, Twitter e no WhatsApp. Ligue agora: Temos os melhores preços com toda a qualidade na divulgação da sua propaganda – WhatsApp: Tim (88) 9.9688-9008.ATENÇÃO:
Olá visitantes e seguidores do nosso site Portal de Notícias Aconteceu Ipu estamos com uma nova plataforma de notícias aberto para sua propaganda com diversos tamanhos de banner’s e preço que cabe no seu bolso. Faça sua propaganda em nosso site e tenha seu produto sendo visualizado diariamente por milhares de internautas que acompanham o nosso trabalho de divulgação, destacados em nossas notícias e nas redes sociais: Instagram, Facebook, Twitter e no WhatsApp. Ligue agora: Temos os melhores preços com toda a qualidade na divulgação da sua propaganda – WhatsApp: Tim (88) 9.9688-9008.ATENÇÃO: ![]()
![]() ➡ SE INSCREVA NO NOSSO CANAL DE VÍDEOS NO YOUTUBE – Notícias – Clique Aqui
➡ SE INSCREVA NO NOSSO CANAL DE VÍDEOS NO YOUTUBE – Notícias – Clique Aqui ![]() ➡ CANAL DE VÍDEOS NO YOUTUBE – Drone – Voando alto – Clique Aqui
➡ CANAL DE VÍDEOS NO YOUTUBE – Drone – Voando alto – Clique Aqui![]() SIGA o nosso novo contato no INSTAGRAM – Click Aqui 🙂
SIGA o nosso novo contato no INSTAGRAM – Click Aqui 🙂